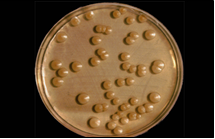
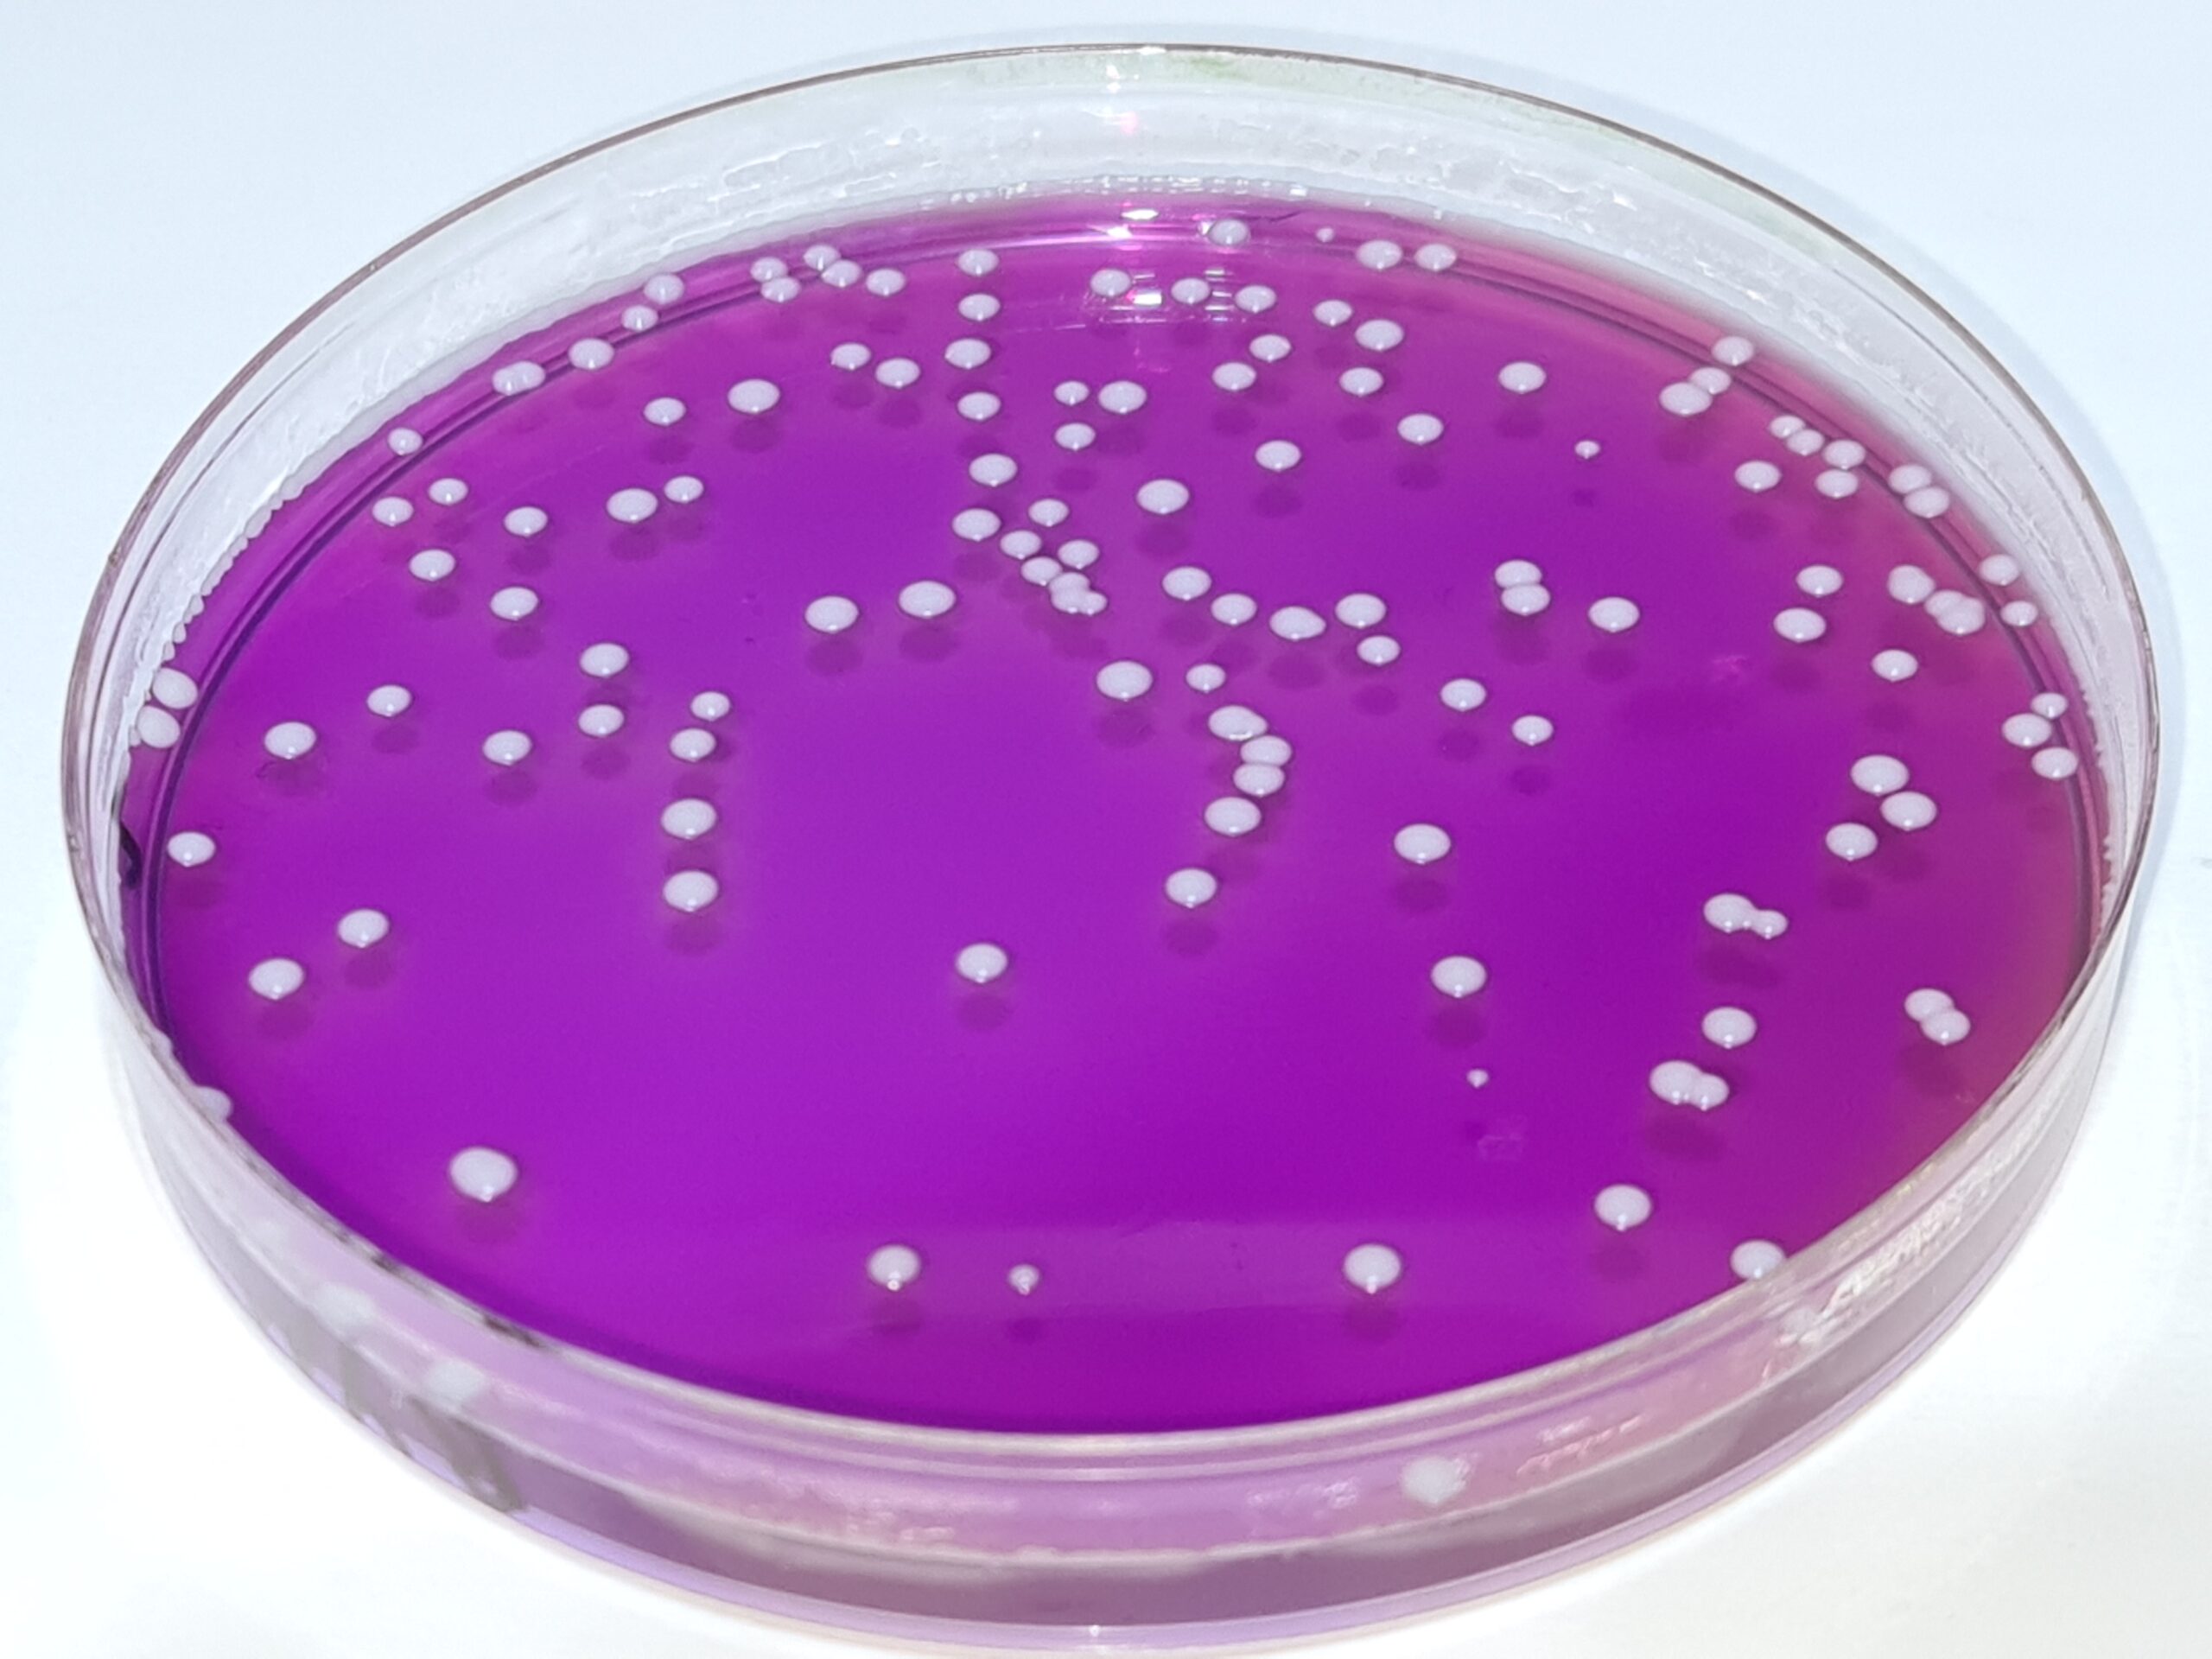

Cepas de Candida albicans, cuantitativas, levadura para control de calidad de los medios de cultivo para hongos, Challenge test, validaciones…
Cepas de Candida albicans
La levadura Candida albicans es un comensal del cuerpo humano que, en determinadas circunstancias, adquiere forma filamentosa, volviéndose entonces patógena oportunista en las mucosas y puede generar picores, malestar y también puede provocar infecciones sistémicas.
Se multiplica por gemación y a veces de sus células globosas emite filamentos, aunque esto sólo sucede cuando entra en fase patógena. Por eso su distinción al microscopio no siempre es certera.
Para saber más, sobre el método diseñado por MICROKIT, en base a su bacdive, para conocer con certeza si una colonia es o no de Candida albicans:
https://www.medioscultivo.com/confirmacion-de-candida-albicans/
Crecimiento con turbidez, viraje de color y/o gas en la campana
Cepas disponibles en stock para entrega inmediata
MICROKIT pone a su disposición la cepa cuantitativa de Candida albicans en formato lentícula estabilizada, con el doble de vida útil que la mayoría de cepas cuantitativas (en nuestro caso, 2 años de caducidad desde fabricación):
WDCM 00054 (es la misma, con nomenclatura universal, que la 10231de la colección de USA que aparece en Farmacopea)
Con excelente capacidad de conservación, dado que las fabricamos con un sistema que no las maltrata, como lo hace la liofilización, sino que las mima.
Medios de cultivo para detectar Candida albicans
Los medios más usados para su aislamiento en placa, por su mención en Farmacopea, Normas ISO y demás bibliografía, son el Sabouraud Dextrose Agar (con o sin Cloranfenicol), el Rosa Bengala Caf Agar, el Potato Dextrose Agar y el Biggy Nickerson Agar:
https://www.microkit.es/fichas/SABOURAUD-DEXTROSE-AGAR.pdf
https://www.microkit.es/fichas/SABOURAUD-DEXTROSE-CAF-AGAR.pdf
https://www.microkit.es/fichas/ROSA-BENGALA-CLORANFENICOL-AGAR.pdf
https://www.microkit.es/fichas/POTATO-DEXTROSE-AGAR.pdf
Más selectivo y diferencial para Candida albicans es el Biggy:
https://www.medioscultivo.com/biggy-nickerson-candida-agar/
En la foto se observa un muy mejor crecimiento de Candida albicans en superficie que en masa en Biggy, aunque sucede lo mismo en todos los medios de cultivo: es muy aerófila
Y con Czapek Dox Agar podemos estimular la esporulación y la generación de filamentos:
https://www.microkit.es/fichas/CZAPEK-DOX-AGAR.pdf
Tambien merece mención el Rapid Sabouraud RYM Agar, donde Candida albicans crece con colonias muy fácilmente reconocibles por su tono azul celeste:
https://www.medioscultivo.com/sabouraud-rapid-ym-agar-rym-hongos-18-48h/
Confirmación de colonias sospechosas
No recomendamos en este caso la ambigua microscopia, ya que si la colonia no está filamentando, vamos a obtener falsos negativos. Ni los medios cromogénicos, ya que se crearon para distinguir distintas especies de Candida en microbiología clínica (cepas patógenas en fase exponencial de crecimiento) y no funcionan bien en muestras inhibidoras como sucede en farmacosmética.
La galerías de identificación (Ej: Rapid-YM) son caras y redundantes, un despilfarro, ya que no se diseñaron para confirmar Candida albicans, sino para distinguir e identificar muchas especies de diferentes levaduras. Fuera de la microbiología clínica y el I+D, no necesitamos saber qué nombre tiene la levadura obtenida, sólo necesitamos saber si se trata o no de Candida albicans.
La mejor opción disponible para confirmar colonias sospechosas obtenidas en cualquier medio, es usar los tubos de M-Ident Candi, que incluyen todas las pruebas Bacdive que distinguen Candida albicans de otras levaduras e incluso de bacterias:
https://www.medioscultivo.com/confirmacion-de-candida-albicans/
Crecimiento con turbidez, viraje de color rojizo a amarillento y/o gas en la campana
Contacto
Todas estos medios mencionados, asi como la cepa (y otras muchas), los tenemos en nuestras instalaciones en stock para entrega inmediata. Solicite la lista actualizada de stock de cepas cuantitativas para consultar las concentraciones y caducidades, antes de realizar sus pedidos, en microkit@microkit.es.
Consulte el folleto:
https://www.microkit.es/pdf/CEPAS-CUANTITATIVAS-2022.pdf
y el video:
Haga sus pedidos de cepas en: pedidos@microkit.es
Cepas cuantitativas de MICROKIT, la únicas lentículas cuantitativas fabricadas en España, desde hace más de 15 años, bajo Norma ISO 9001 y siguiendo las directrices sobre la competencia de los fabricantes de material de referencia (ISO 17034).